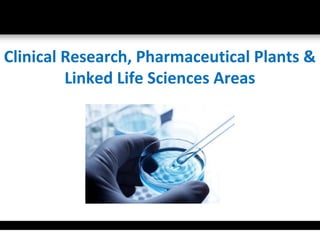

Clinical research, pharmaceutical plants, and related life sciences areas face both challenges and opportunities. More customer centricity is needed as patients are more concerned with healthcare management and cost-effective treatment solutions. Marketing strategies must adapt to changes in digital marketing and web 2.0 to better engage customers. Governments are increasing regulation and oversight of the healthcare sector to ensure ethics, quality, and compliance. The introduction of new medicines and preventative tools has allowed many critical illnesses and diseases to be treated or prevented, benefiting patients worldwide.